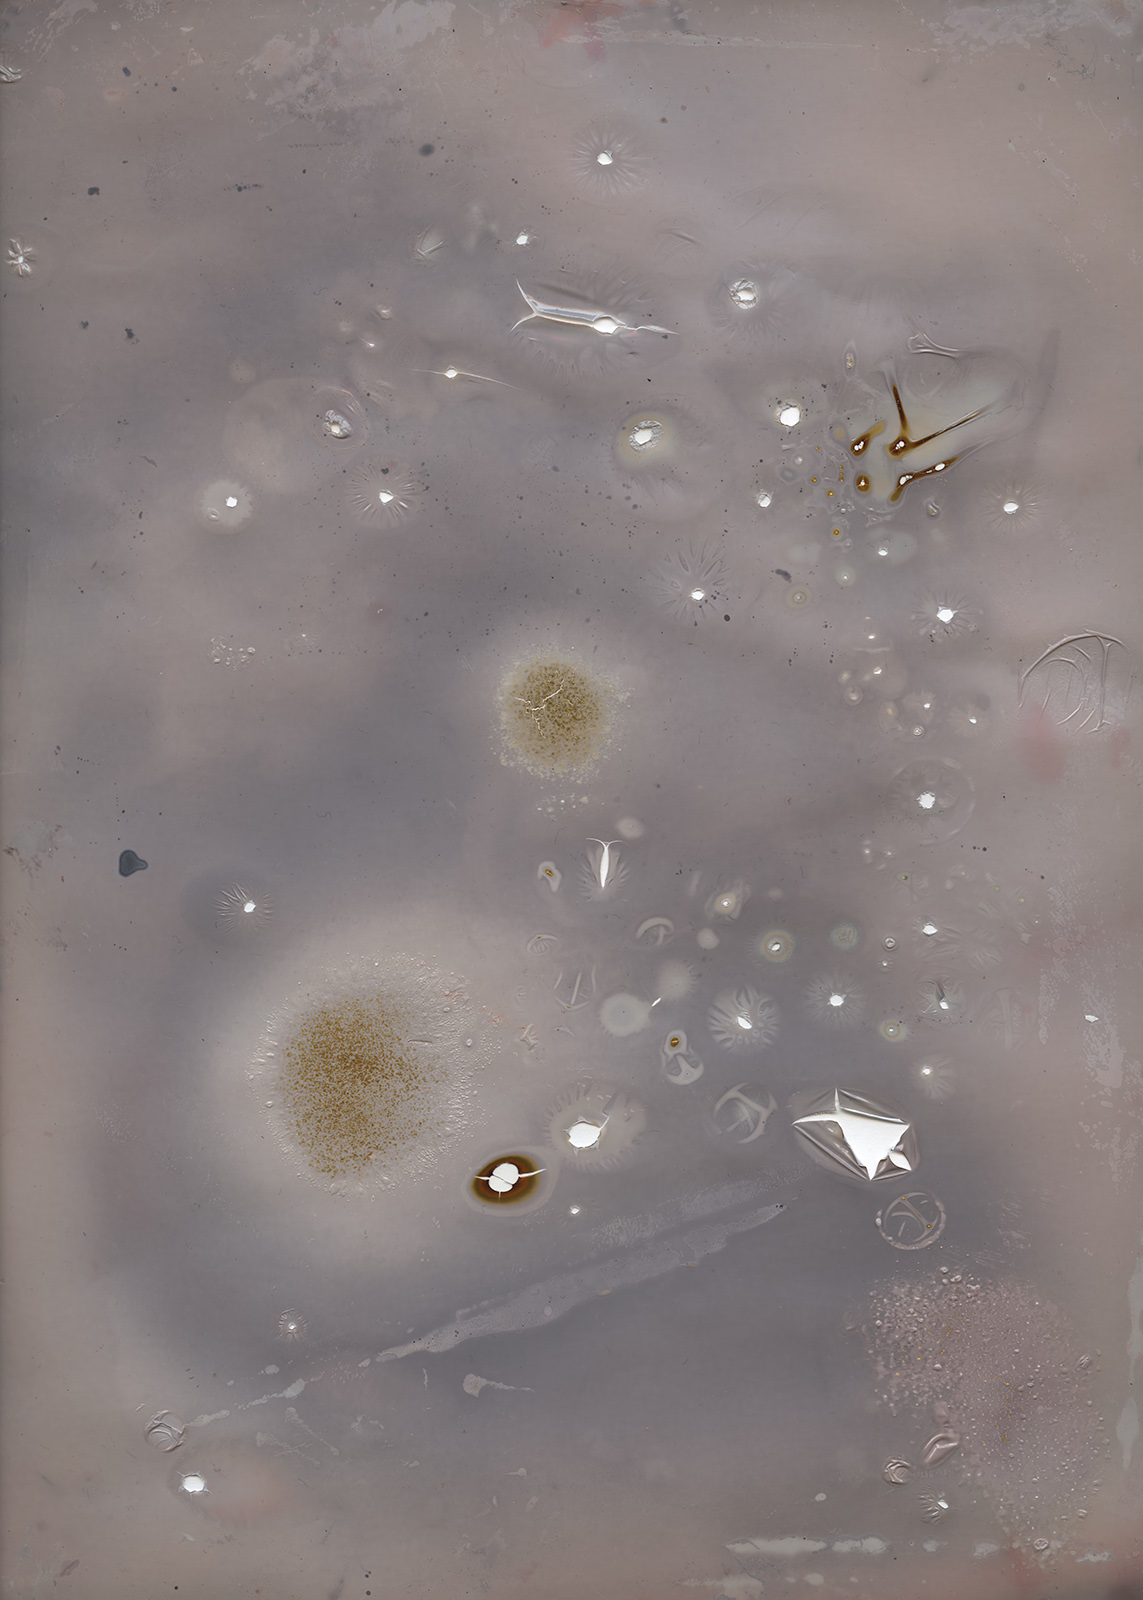

Things Image
photography and video series ︎ 2014-2016
So what about those images? The present time is overfull of those all pictures. Many discourses about visuality feud about the monopoly of existence. Image as an object, as the fact, indeed as a medium; models, divisions, considerations. The need to provide information, as a defined image and reality. Much, more, more. All of this. The excess. So, if all photos transfer to a state of slavery, then… only Nature will remain.
The works are the result of the interests and experiments concerning the relationship between the aspect of excess, especially in the case of photography (and the visual) and the transformation in the areas of the nature of the photographic medium. After three years of Photography studies, I decided to burn all the images from the individual laboratories to transfer them to nothingness and leave the space, that a picture describes. Simultaneously, in an attempt to explore and recognize the mode of existence, in which such matter is confined, and in the area of what and according to what does it exist. During all of this process, when different kind of photo material were melting and joining and dissappear by burning, they also started to create different spacial objects. This new transformation as the objects I decided to safe and finnally document them by photography medium. Incineration, in particular such material, that photos and the photo paper itself are, is a symbol of forgeting. However, rather it is only an illusion.
That part of process has opened new area of experiments and questioning. Burning itself has become a process not only provoking to the destruction, but especially creating, thus releasing the schemes and activating matter. In such a process of transformation is difficult to predict the consequences and it is impossible to undo these changes, which occured. At the same time the effect is not the result of planning. It is the effect of actions of matter, which is not accidental however. It is a complex process of physical entities - light, time, temperature, image, information, perception... As a result of this, it becomes important to direct awareness to what there arises, simultaneously paying attention to being in the relationship between volatility of the image changeability, which remains an illusion after. As a result of that transformations the objects - traces were created, whose images tend to their own existence. Overfilled remnant of something previous, they are became new memory carrier.